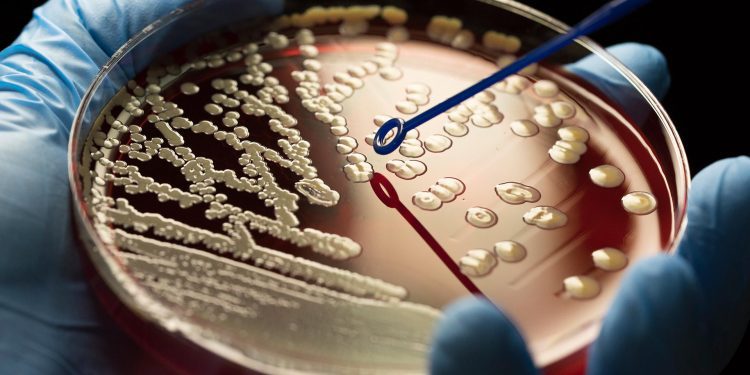
Expertos advierten que la resistencia a los antimicrobianos podría ser la próxima pandemia mundial

En seminario realizado en la Universidad de Talca, especialistas abordaron distintas estrategias para la detección y control de la resistencia antimicrobiana.
La resistencia a los antimicrobianos y el combate de los hongos en los alimentos fueron los temas principales abordados en el Simposio de Microbiología titulado “Desde el laboratorio a las aplicaciones biomédicas”, organizado por el Doctorado de Ciencias Biomédicas (DCBM) y el Departamento de Microbiología de la Universidad de Talca, y que contó con expositores de diversas instituciones y áreas, tanto nacionales como internacionales.
En la oportunidad se presentó Aura Villamil Pérez, representante de la Organización Panamericana de la Salud (OPS) y del Instituto de Salud Pública (ISP) Chile, con el tema “Acción Global en Salud para la detección y control de la Resistencia Antimicrobiana en Chile”.
La profesional explicó que, “es muy importante difundir este tema porque está considera como la próxima pandemia que se va a dar a nivel mundial, y se ha dado de manera gradual y silenciosa. El problema radica en que va a llegar el momento en que las bacterias que causan infecciones, tanto a nivel humano como veterinario, no van a tener antibióticos que sean capaces de contrarrestarlos. Por lo tanto, van a aumentar las muertes causadas por este tipo de bacterias”.
Para evitar este escenario, dijo Villamil, “se debe dar un buen uso a los antimicrobianos siguiendo las indicaciones de los médicos: cuando indican el consumo de antibióticos, en cuanto al tiempo y horario que se debe seguir y no tomarlos sin prescripción médica”.
Según indicó, el problema se generó ya que se trata de un “mecanismo natural de los microorganismos, que tratan de subsistir buscando la manera de sobrevivir frente al uso de antimicrobianos, así que comienzan a generar mecanismos de resistencia”.
Justamente el académico del Departamento de Microbiología y del DCBM UTalca, Esteban Durán, se dedica a este tema, por lo que presentó la ponencia “Desarrollo de Nanoantibióticos: la Nueva Estrategia contra la Resistencia Bacteriana”, en la cual da cuenta sobre los estudios realizados en esta temática.
“Mi línea de investigación -que es multidisciplinaria- aborda principalmente la búsqueda de nuevas estrategias para combatir la resistencia de microorganismos, a través del diseño y desarrollo racional de hidrogeles basados en nano y biomateriales como sistemas avanzados de administración de fármacos y/o compuestos bioactivos. Y, por otro lado, me dedico al diseño y desarrollo de nanopartículas metálicas con actividad antimicrobiana basados en nano y biomateriales asociados al concepto de nanoantibioticos”, dijo.
Además, agregó que “en nuestro BioNanoLab desarrollamos líneas de desarrollo de terapias inteligentes anticancerígenas y al desarrollo de sistemas de nanodiagnóstico para enfermedades infecciosas y cancerígenas”.
Hongos
Por otra parte, la profesora Verónica Carrasco Sánchez, mostró el trabajo que realiza ligado al control de hongos en los alimentos, específicamente en el vino. Se trata de identificar las micotoxinas que afectan a la industria local y poder eliminarlas de los productos (sin afectar la calidad del producto), con elementos extraídos de desechos agroindustriales, ya que el consumo sostenido en el tiempo de alimentos afectados con estos hongos puede provocar cáncer.
Con relación a esto, la académica obtuvo en junio de este año recursos del FIC Ñuble, que le permitirá ejecutar el proyecto “Identidad Microbiana de la Viticultura del Itata”.
Tendencias y novedades
Sobre la actividad, el director del citado doctorado, Rodrigo Moore, detalló que buscó generar un espacio de conversación “para conocer las últimas tendencias del área de la Microbiología, de sus aplicaciones biomédicas y también de algunas aplicaciones industriales”.
“Al mismo tiempo, y lo más importante, es que queremos dar a conocer lo que están haciendo nuestros profesores. Tenemos tres académicos que están con proyectos, que son muy productivos y activos en el área de la investigación y queremos que la comunidad del doctorado y la comunidad académica de la UTalca los conozca”.
En ese sentido, el DCBM tiene como propósito formar investigadores independientes y está dirigido a profesionales de las ciencias biomédicas, contemplando el desarrollo de una tesis enmarcada en las áreas de Fisiopatología y la ya mencionada Microbiología, o de Hematología e Inmunología. Las postulaciones para este programa están abiertas en su sitio web.